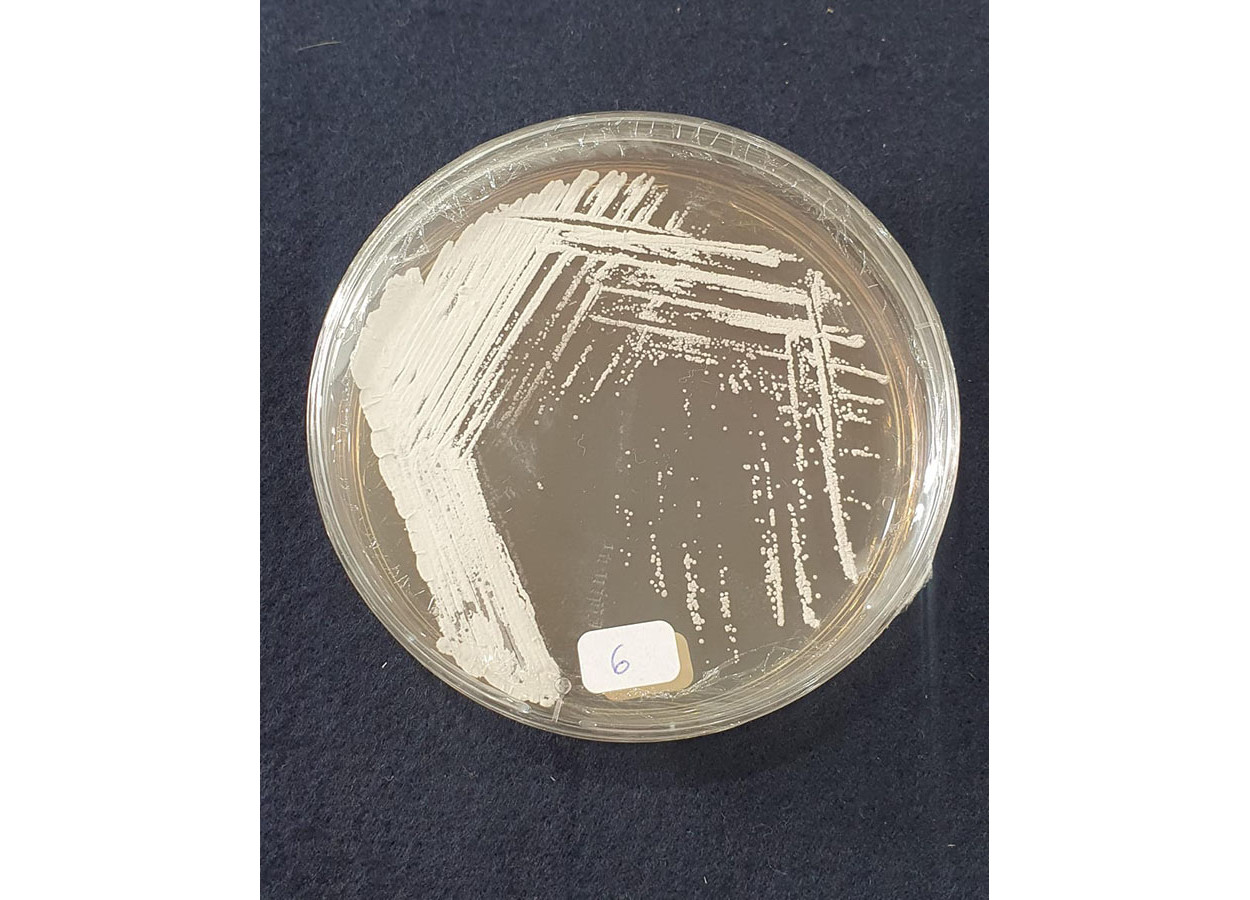
Foto: Danilo Tosta

Nova nectarina da Embrapa chega ao mercado nacional
BRS Carina complementa o calendário de colheita e atrai produtores e consumidores pela qualidade da fruta
Uma bactéria isolada de solos da Caatinga apresentou forte ação herbicida contra a buva (Conyza canadensis). A descoberta envolve uma cepa do gênero Streptomyces e aponta para o desenvolvimento de bioherbicida.
Pesquisadores da Embrapa Meio Ambiente e da Universidade de São Paulo, campus de Ribeirão Preto, identificaram moléculas naturais produzidas pela bactéria capazes de inibir a germinação da buva.
A buva ocorre em praticamente todas as regiões do país e já não responde a alguns herbicidas. Esse cenário eleva custos de produção, reduz produtividade e amplia riscos ambientais. A pesquisa busca alternativas naturais para o manejo de plantas daninhas e para a redução da dependência de defensivos sintéticos.
O trabalho partiu da triagem de actinobactérias oriundas de diferentes biomas brasileiros. A cepa Streptomyces sp. Caat 7-52, isolada na Caatinga, destacou-se por produzir compostos com forte efeito fitotóxico.
A análise química identificou dois compostos principais. O ácido 3-hidroxibenzóico. E a albociclina. Essa última teve a atividade herbicida descrita pela primeira vez. Em testes, a albociclina inibiu a germinação da buva em baixas concentrações, a partir de 6,25 µg/mL.
Os pesquisadores também ajustaram o meio de cultivo da bactéria em laboratório. A estratégia aumentou o rendimento e a diversidade das moléculas bioativas. Esse passo favorece a futura produção em escala de um bioherbicida.
Além das moléculas isoladas, o caldo fermentado bruto da bactéria apresentou efeito seletivo contra plantas daninhas dicotiledôneas. O resultado ocorreu sem uso de solventes químicos. A abordagem reduz etapas de processamento e pode diminuir custos, além de evitar insumos industriais.
A equipe prevê testes em condições de campo, avaliações em diferentes culturas, estudos de ecotoxicologia e desenvolvimento de formulações comerciais. A proposta envolve a integração da tecnologia a programas de manejo integrado de plantas daninhas, com foco em produtividade e sustentabilidade.

Receba por e-mail as últimas notícias sobre agricultura